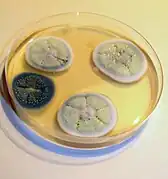

Culture plate
In microbiology, a culture plate is a low flat-bottomed laboratory container for growing a layer of organisms such as bacteria, molds, and cells on a thin layer of nutrient medium. The most common types are the petri dish[1][2] and multiwell plates.[3]
![]() |
![]() |
See also
- Roux culture bottle
- Inoculation loop
- Test tube
References
- ↑ Dubey, Dr R. C. (5 November 2018). A Textbook of Biotechnology For Class XI. S. Chand Publishing. p. 469. ISBN 9788121924177.
- ↑ "Square Petri Dish with Grid". Thomas Scientific Online Catalog. Thomas Scientific. 2019. Archived from the original on 19 August 2022. Retrieved 25 October 2019.
- ↑ "Cell Culture Plates". Thermo Fisher Online Catalog. Thermo Fisher Scientific. July 2017. Archived from the original on 26 October 2019. Retrieved 25 October 2019.